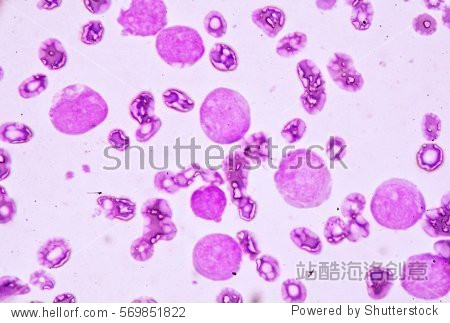
blood smear under microscopy showing on adult acute myeloid

cervicalsmear

what does hsil look like on pap smear cytology?
图片尺寸500x375
单细胞rt-pcr:二次pcr产生严重smear条带,求助怎么解决?
图片尺寸1355x911
源面霜 confidence in a cream hydrating moisturizer product smear
图片尺寸1150x1150
lawsuit alleges managers of allergan engaged in smear campaign
图片尺寸1020x574
蚕豆叶下表皮装片学生显微镜下观察中考生物实验教材同步观察玻片
图片尺寸750x467
two cervical cancer cells divide in this image from a scanning
图片尺寸1800x1011
人类乳头瘤病毒
图片尺寸220x187
tzanck smear from a vesicle on the right arm.
图片尺寸785x785
peripheral-blood smear and biopsy specimens of bone marrow and
图片尺寸1536x1742
blood smear under microscopy showing on adult acute myeloid
图片尺寸450x323
phototake_rm_photo_of_pap_smear_test
图片尺寸493x335
kind of white blood cell in peripheral blood smear
图片尺寸450x358
disposable cervical smear b
图片尺寸700x550
gynaecologist performing a cervical smear
图片尺寸615x410
ok medical instrument disposable cervical smear type c
图片尺寸600x600
dns-
图片尺寸680x510
组胚红蓝铅笔绘图
图片尺寸1492x1601
【求助】3-race出来的是smear.
图片尺寸656x796
535-eosinophilia-peripheral-blood-smear-s129-springer-arrows
图片尺寸704x527
segmentation of cervical nuclei in pap smear images using
图片尺寸1243x769